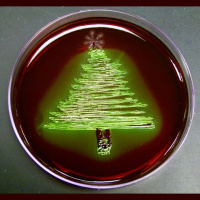
60 - Santas Salmonella

Sinopsis
Bedside Rounds is a tiny podcast about fascinating stories in clinical medicine. We discuss the weird, wonderful, and human stories that have affected patients and their doctors throughout history and today.
Episodios
-
74 - R2D2
03/09/2023 Duración: 33minWhat does it mean when a computer can make better medical decisions than a human? The progress in large language models, and in particular the popularity of ChatGPT, has brought these questions to the forefront in 2023, but we’ve been discussing this for over 50 years. In this episode, Dr. Shani Herzig and I are going all the way back to the early 1970s with the invention of AAPHELP, the first real clinical decision support system, and the first time doctors had to contemplate working with – or competing against – computer systems.
-
73 - Seadragon
26/06/2023 Duración: 27minWhat happens when a patient far from surgical care – say, at the bottom of the Pacific ocean on a submarine, or at a research base in Antarctica in the middle of the winter – develops a surgical abdomen? This dilemma was the impetus to build the first truly effective clinical decision support system – and to grapple with what it means when a computer can make better medical decisions than a doctor. In this episode, part one of three, we discuss the dramatic stories of appendectomies at Novolazarevskaya and aboard the submarine Seadragon. Also, there’s a brand new #AdamAnswers about the origin of the word “scut.”
-
72 - Problems
20/03/2023 Duración: 52minAmerican doctors spend the majority of their time during the day on the computer, either writing or reading notes about their patients; only a small fraction is spent with the human beings in their care. Technology itself – especially the electronic medical record – has often been blamed for this. But in this episode – a recorded grand rounds that I gave at the San Francisco VA in 2022 – I argue that this alienation has its roots in the way we’ve decided to organize clinical data, and the assumptions that we’ve made about the nature of medical care. In particular, I’m going to discuss one of the most influential medical thinkers of the second half of the 20th century, Larry Weed, his invention of the problem-oriented medical record and the SOAP note, and how his insight – that medical documentation fundamentally influences how we think about our patients – changed the way we think about our patients.
-
71 - A Doctor's Work, part 2
16/01/2023 Duración: 37minIn the past episode, cultural and medical historians Lakshmi Krishnan and Mike Neuss discussed the history of the actual work of the doctor – Holmesian detective, data entry clerk, or something else altogether. In this episode, we conclude our discussion by talking about what type of metaphors are best suited for clinical work. Plus a brand new #AdamAnswers about the reason that American doctors are so obsessed with using, well, the # symbol in our notes.
-
70 - A Doctor's Work
19/12/2022 Duración: 49minWhat do doctors actually do? Are they Sherlockian detectives, hunting down obscure clues to solve intractable cases? Are they virtuosic experts, training for half a lifetime to bring the latest science to bear to cure disease? Or are they clerks, whose main job is to collect and enter data into the electronic health record? In this episode, Adam is joined by medical and cultural historians Lakshmi Krishnan and Mike Neuss to discuss the stories we tell about our own work – and how this often conflicts with the realities of clinical practice.
-
69 - The Database
31/10/2022 Duración: 48minHow do doctors actually think? And if we can answer that, can we train a computer to do a better job? In the post-WW2 period, a group of iconoclastic physicians set about to redefine the nature and structure of clinical reasoning and tried to build a diagnostic machine. Though they would ultimately fail, their failure set the stage for the birth of the electronic health records, formalized the review of systems, and set up a metacognitive conflict that remains unresolved to this day. This episode, entitled “The Database,” is the second part of this on the history of diagnosis with Gurpreet Dhaliwal.
-
68 - The History
25/07/2022 Duración: 39minInternal medicine physicians like to pride ourselves on our clinical reasoning – the ability to talk to any patient, pluck out seemingly random bits of information, and make a mystery diagnosis. But how does this actually work? In this episode, called The History, I’ll be joined by Gurpreet Dhaliwal as we explore the beginnings of our understanding on how clinical reasoning works – starting in the middle of the 19th century with polar tensions between two ways of approaching our patients that are still felt today. Along the way, we’ll talk about the American Civil War, Car Talk, Sherlock Holmes, and whether the practice of medicine can ever be considered a science. Sign up for Digital Education 2022 here: https://cmecatalog.hms.harvard.edu/digital-education Sources: Fitzgerald F, Curiosity. https://www.acpjournals.org/doi/full/10.7326/0003-4819-130-1-199901050-00015 Montgomery K, How Doctors Thinks (amazon link: https://www.amazon.com/How-Doctors-Think-Clinical-Judgment/dp/0195187121) Da Costa J, Medical D
-
The Facemaker with Dr. Lindsey Fitzharris (#histmedconsultservice)
07/06/2022 Duración: 51minModern plastic surgery was born out of the horrors of trench warfare in World War I. In this episode, Adam interviews historian Lindsey Fitzharris about her new book The Facemaker, about the life of surgeon Harold Gillies and his quest to rebuild his patients' faces.
-
67 - Fever on the Frontier
21/03/2022 Duración: 48minIn the early 19th century, a strange new illness, seemingly unknown to medicine, ravaged settler communities in the American Middle West. As fierce debates about this new disease, now called milk sickness, raged – was it from toxic swamp gasses? arsenic in the soil? infectious microorganisms? from the poor constitutions of the settlers – an irregular medicine woman named Dr. Anna and an indigenous Shawnee healer discovered the cause of the disease and successfully prevented it in their community. But their discovery went unheeded for over a half century. This is a live podcast that I gave to the South Dakota chapter of the American College of Physicians – plus a new Stethospeaks with Dr. Umme H. Faisal on the history of Resusci-Annie’s mysteriously serene face! Teepublic store: https://www.teepublic.com/stores/bedsiderounds Sources: DOYLE JT. Milk sickness. N C Med J. 1947 Jul;8(7):404-10. PMID: 20250350. Furbee L, Snively WD Jr. Milk sickness, 1811-1966: a bibliography. J Hist Med Allied Sci. 1968 Jul;2
-
66 - Burnout
08/01/2022 Duración: 53minBurnout seems to stalk healthcare workers; between a third and a half of doctors and nurses had symptoms of burnout BEFORE the COVID-19 pandemic. Major medical associations have recognized burnout as a serious problem and the condition is being added to ICD-11 as an “occupational phenomenon.” How did we get ourselves into this situation? How has burnout gotten so bad? In this episode, the first #HistMedConsultService, I’m joined by historians of healthcare and emotions Agnes Arnold-Forster and Sam Schotland to historicize burnout. Along the way, we’ll talk about the different structural factors that have colored burnout in North America and the United Kingdom; the disgruntled pediatrician syndrome, physician “impairment”, whether burnout is a disease, and what we might all be able to do to make everyone less miserable. Sources: https://www.nejm.org/doi/pdf/10.1056/NEJMp2112095 https://www.washingtonpost.com/outlook/2021/04/29/covid-19-only-exacerbated-longer-pattern-healthcare-worker-stress/
-
65 - The Last Breath
05/11/2021 Duración: 40minHow can we medically tell whether or not someone is alive or dead? The answer is much more complicated than you'd think. In this episode, which is a live podcast I gave with Tony Breu at the Massachusetts Chapter of the American College of Physicians annual meeting on October 16, 2021, we track the evolution and controversies of the death exam, from a trans-Atlantic scandal surrounding a possible vivisection, a 19th century “X-prize” to determine a technology that could diagnose death, the important distinction between “permanent” and irreversible, and the mysterious Lazarus phenomenon. References: Rodman A, Breu A. The last breath: historical controversies surrounding determination of cardiopulmonary death. Chest. 2021; [online ahead of print August 13, 2021]. https://doi.org/10.1016/j.chest.2021.08.006
-
64 - A Vicious Circle
04/10/2021 Duración: 40minDuring World War II, the US Army launched a seemingly routine experiment to find the ideal way to screen soldiers for tuberculosis. Jacob Yerushalmy, the statistician in charge of this project, would succeed at this task -- and end up fundamentally changing our conception of medical diagnosis in the process. This episode features Dr. Shani Herzig, as well as a new segment featuring Dr. Umme H. Faisal on Yellapragada Subbarow and his discovery of ATP. Bedside Rounds store: https://www.teepublic.com/stores/bedsiderounds Umme H. Faisal on Twitter: @stethospeaks
-
63 - Signals
23/08/2021 Duración: 40minWhat does it mean when different physicians disagree about a diagnosis? I am joined by Dr. Shani Herzig as we explore this issue in the second part of my series on the development of diagnosis. We’re going to discuss the advent of signal detection theory in the middle of the 20th century as new diagnostics such as laboratory testing and x-rays started to challenge the classical view of diagnosis. Along the way, we’re going to talk about focal infection theory and why it seems that everyone in older generations had their tonsils removed as children, early and very inefficient chest x-rays, British radar operators trying to figure out if they were looking at a flock of geese or a German bomber, and finally probably one of the most important people in medical diagnostics that you’ve never heard of -- Jacob Yerushalmy. If you want to purchase any Bedside Rounds swag, the store is at https://www.teepublic.com/stores/bedsiderounds.
-
62 - The Sisters Blackwell
10/05/2021 Duración: 41minElizabeth Blackwell -- the first woman to earn a medical degree in the United States -- and her sister Emily Blackwell are some of the most important physicians of the 19th century, firmly establishing the role of women as physicians, starting an infirmary and hospital for poor women and children, and founding a women’s medical college that was decades ahead of its time. In this episode, Dr. Nora Taranto joins me to explore the legacy of the Blackwells along with Janice Nimura, who recently published a biography of the sisters.
-
61 - Etymologies
29/03/2021 Duración: 39minWords matter. At its best, etymology gives us insight not only into the origins of words, but why they remain so important today, especially in medicine, where we’ve been accruing jargon for millennia. In this episode, we’re delving into four specific words -- doctor, cerebrovascular accident, rounds, and zebras. And along the way, we’re going to discuss pre-historical pastoralists on the Eurasian steppes, medieval universities, Octagonal air-ventilated chambers in 19th century Baltimore, and of course, early 21st century sitcoms. Works cited: OSLER W. THE NATURAL METHOD OF TEACHING THE SUBJECT OF MEDICINE. JAMA. 1901;XXXVI(24):1673–1679. doi:10.1001/jama.1901.52470240001001 Fair, A 2014, 'A Laboratory of Heating and Ventilation: The Johns Hopkins Hospital as experimental architecture, 1870–90', The Journal of Architecture, vol. 19, no. 3, pp. 357-81. https://doi.org/10.1080/13602365.2014.930063 Engelhardt E. Apoplexy, cerebrovascular disease, and stroke: Historical evolution of terms and definitions. Dem
-
60 - Santa's Salmonella
24/12/2020 Duración: 38minFor a special holiday treat, we’re going to explore two tales of salmonella disease detectives -- the first about Mary Mallon (“Typhoid Mary”) and the birth of the genre; and the second about a mysterious salmonella outbreak at Massachusetts General Hospital solved with the assistance of a very jolly patient. Along the way, we’ll talk about clinical epidemiology, the long-lasting influence of Berton Roueché, and the joys of being an internist! You can sign up for the Digital Education conference at cmeregistration.hms.harvard.edu/digitaleducation. Sources: Buckle GC, Fischer Walker CL, and Black RE, Typhoid fever and paratyphoid fever: Systematic review to estimate global morbidity and mortality for 2010.J Glob Health. 2012 Jun; 2(1): 010401. Marineli F et al, Mary Mallon (1869-1938) and the history of typhoid fever.Ann Gastroenterol. 2013; 26(2): 132–134. Soper GA, The Curious Career of Typhoid Mary, read on May 10, 1939 before the Section of Historical and Cultural Medicine. Retrieved from: https://
-
59 - Cry of the Suffering Organs
30/11/2020 Duración: 43minDiagnosis is arguably the most important job of a physician. But what does it actually mean to make a diagnosis? In this episode, we’ll explore this question by tracking the development of the “classical” model of diagnosis and pathological anatomy and discussing three cases over three hundred years. Along the way, we’ll ponder the concept of the lesion, iatromechanistic theories of the human machine, the birth of the International Classification of Diseases, and the rise and decline of the autopsy. You can sign up for the iMED Digital Education conference at cmeregistration.hms.harvard.edu/digitaleducation. Sources: Hooper R, The Physician’s Vade-Mecum: Containing the Symptoms, Causes, Diagnosis, Prognosis and Treatment of Diseases. 1812. Holdman L et al, The Value of the Autopsy in Three Medical Eras. N Engl J Med 1983; 308:1000-1005. Cabot RC et al. CASE RECORDS OF THE MASSACHUSETTS GENERAL HOSPITALANTE-MORTEM AND POST-MORTEM RECORDS AS USED IN WEEKLY CLINICO-PATHOLOGICAL EXERCISES. Case 9431. Boston M
-
The House of Pod: How medical podcasting made me a better doctor and educator … and how it might change the future of medical education for everyone
23/11/2020 Duración: 38minIn this episode, I talk about my podcasting journey -- how I started Bedside Rounds for inspiration during a low period in residency, how it changed me as a physician, and how it has changed my views about digital education and the future of medical education in general. This is a live recording of a talk I gave at the Michigan ACP annual meeting last month. Also, we are hosting the first annual iMED conference in January (virtual this year, of course) -- the link is cmeregistration.hms.harvard.edu/digitaleducation to sign up!
-
58 - The Original (Antigenic) Sin
26/10/2020 Duración: 55minThe COVID-19 pandemic laid bare the racial health disparities in the United States, with markedly increased mortality especially among Blacks and Native Americans. In this episode, Tony Breu and I discuss the conception of race, racism, and the social determinants of health through three historic plagues in the United States -- from yellow fever in New Orleans, to poliomyelitis, and finally the early days of HIV/AIDS -- and what lessons we can draw for COVID-19. Along the way, we’ll discuss the unique social capital afforded by acclimation, immunity passports, the concept of the “original antigenic sin,” and constitutionalism and eugenics. This presentation was performed live at the annual meeting of the Massachusetts American College of Physicians, and is only lightly edited. SOURCES: Monath TP, Yellow fever: an update. Lancet Infect Dis. 2001 Aug;1(1):11-20. doi: 10.1016/S1473-3099(01)00016-0. Kallas EG, D'Elia Zanella LGFAB, Moreira CHV, Buccheri R, Diniz GBF, Castiñeiras ACP, Costa PR, Dias JZC, Marm
-
57 - The Second Wave
31/08/2020 Duración: 45minIn August of 1918, a horrific second wave of the Spanish Flu crashed across the world. In this episode, the third of a four-part series exploring hydroxychloroquine and COVID-19, I’ll explore this single moment in time, through the mysterious origins of the Spanish Flu and historiographical controversies, scientific missions to mass burial sites in remote Alaskan villages, the ill-fated journey of the HMS Mantua, debates about how to count victims of a pandemic, and the mystery behind Pfeiffer’s bacillus. Plus a new #AdamAnswers about that annoying yellow on blue powerpoint template so common in the medical field! Sources: Viboud, C. et al. Age- and Sex-Specific Mortality Associated With the 1918–1919 Influenza Pandemic in Kentucky. J Infect Dis 207, 721–729 (2013). Oxford, J. S. & Gill, D. A possible European origin of the Spanish influenza and the first attempts to reduce mortality to combat superinfecting bacteria: an opinion from a virologist and a military historian. Hum Vacc Immunother 15, 2009–2